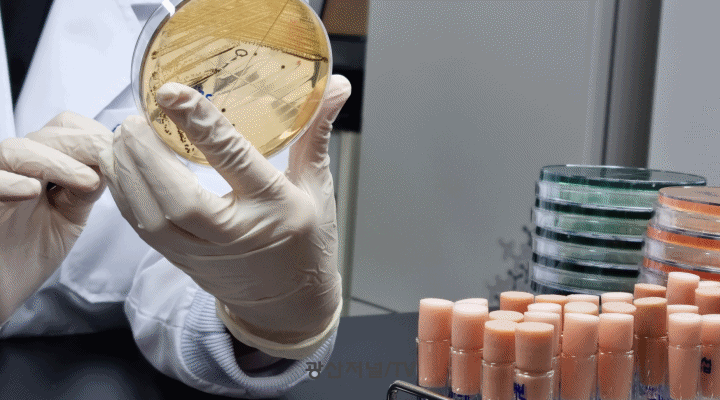

[종합] 광주시, 충민공 제396주기 제향 봉행 |2023. 10.19 [종합] 광주시, 충민공 제396주기 제향 봉행 |2023. 10.19
[광산저널] 광주광역시(시장 강기정)는 19일 충민공 전상의 장군 제396주기를 맞아 충민사 영당 앞에서 호국충절의 숭고한 뜻을 기리고 추모하는 제향행사를 개최했다.
전상의 장군은 광해군 9년(1617)에 일본에 건너가 임진왜란과 정… |
|
 [종합] 제32회 광산구민의 날, 최초로 시민 대표가 기념사 |2023. 10.19 [종합] 제32회 광산구민의 날, 최초로 시민 대표가 기념사 |2023. 10.19
[광산저널] 광산시민 모두의 축제인 ‘광산구민의 날’이 진정한 시민 중심 행사로 거듭난다. 내빈 축사, 의전 등을 대폭 축소하고, 특히 광산공동체가 나아갈 방향과 앞으로의 다짐이 담긴 기념사를 처음으로 시민의 목소리로 발표하는 … |
|
 [종합] 광산구어린이급식지원센터, 사랑나무어린이집 원생 체험 교육 |2023. 10.19 [종합] 광산구어린이급식지원센터, 사랑나무어린이집 원생 체험 교육 |2023. 10.19
[광산저널] 광산구어린이·사회복지급식관리지원센터(센터장 양은주, 호남대학교 식품영양학과 교수)는 10월 18일 복지관 1층체험관에서 구립 사랑나무어린이집 원생을 대상으로 ‘아이셰프 클래스’ 영·유아 체험관 교육을 실시했다.
… |
|
 [종합] 광주시, 23∼26일 ‘2023년 화랑훈련’ 실시 |2023. 10.19 [종합] 광주시, 23∼26일 ‘2023년 화랑훈련’ 실시 |2023. 10.19
[광산저널] 광주광역시(시장 강기정)는 지역 통합방위태세 확립을 위한 ‘2023년 화랑훈련’을 오는 23일부터 26일까지 실시한다.
화랑훈련은 민·관·군·경 통합방위 능력을 증대하고, 군 작전 수행능력을 높이기 위해 2년 단위로 … |
|
 [종합] 예술성·대중성 조화…시민에 다가간 미디어아트 |2023. 10.19 [종합] 예술성·대중성 조화…시민에 다가간 미디어아트 |2023. 10.19
[광산저널] ‘2023 광주미디어아트페스티벌’이 성공리에 막을 내렸다.
‘빛도 꿈을 꾸는가’를 주제로 지난 9월5일부터 10월15일까지 광주미디어아트플랫폼(G.MAP)과 야외광장에서 열린 ‘2023 광주미디어아트페스티벌’(이하 2023 … |
|
 [종합] 강기정 시장, 장애인아시안게임 광주선수단 응원 |2023. 10.19 [종합] 강기정 시장, 장애인아시안게임 광주선수단 응원 |2023. 10.19
[광산저널] 강기정 광주광역시장이 ‘2022 항저우 장애인아시안게임’ 개막을 사흘 앞둔 19일 광주시 소속 국가대표 선수와 지도자들을 격려했다.
광주지역 실업 소속으로 출전하는 국가대표 선수단은 탁구·양궁·사격·육상·보치아… |
|
 [종합] 호남대, ‘K-MOOC 미래기술 컨퍼런스 시즌 2’ 개최 |2023. 10.19 [종합] 호남대, ‘K-MOOC 미래기술 컨퍼런스 시즌 2’ 개최 |2023. 10.19
[광산저널] 호남대학교(총장 박상철)가 10월 18일 교내 도서관 1층에 마련된 카페형 학생 쉼터 호스카에서 ‘K-MOOC(한국형 온라인 공개강좌) 명사에게 듣는 미래기술 컨퍼런스 시즌 2’를 개최했다.
이날 오후 1시 30분부터 시작한 … |
|
 [종합] 광주고려인마을 가족식당, 우즈벡 사마르칸트 고려인협회에 전통악기 기증 |2023. 10.19 [종합] 광주고려인마을 가족식당, 우즈벡 사마르칸트 고려인협회에 전통악기 기증 |2023. 10.19
[광산저널] 광주고려인마을에 정착한 후 식당을 시작해 안정을 찾은 우즈베키스탄 출신 고려인동포가 사마르칸트 고려인협회에 전통악기를 기증했다.
18일 고려인마을에 따르면, 기증자는 다름아닌 고려가족식당을 운영하는 전발레르씨… |
|
 [종합] 박상철 호남대 총장, 한국대학스포츠협의회 이사회 참석 |2023. 10.18 [종합] 박상철 호남대 총장, 한국대학스포츠협의회 이사회 참석 |2023. 10.18
[광산저널] 박상철 호남대학교 총장은 10월 18일 포시즌스호텔서울에서 열린 ‘2023년도 한국대학스포츠협의회(KUSF) 임시 이사회’에 참석해 내년도 예산안 등 주요 현안을 심의했다.
한국대학스포츠협의회는 대학 스포츠의 건전한 … |
|
 [종합] 국제거리예술축제 ‘광주프린지페스티벌’ 20일 개막 |2023. 10.18 [종합] 국제거리예술축제 ‘광주프린지페스티벌’ 20일 개막 |2023. 10.18
[광산저널] 광주광역시(시장 강기정)는 20~22일 사흘간 5·18민주광장과 금남로 일원에서 ‘2023 광주프린지페스티벌’(이하 프린지)을 진행한다.
올해로 8회를 맞은 프린지는 ‘거리예술, 꿈같은 일탈’을 주제로 시민들을 만난다.
… |
|
 [종합] 빛고을안전체험관, 시청각자료 활용 소방안전교육 |2023. 10.18 [종합] 빛고을안전체험관, 시청각자료 활용 소방안전교육 |2023. 10.18
[광산저널] 광주광역시빛고을국민안전체험관은 18일 비문해자와 문해교육기관 관계자 대상으로 소방안전 체험교육을 실시했다.
이날 교육은 24명의 비문해자들이 참석해 호우·화재안전 등 재난상황별 행동요령과 생활 속 안전사고 예… |
|
 [종합] 광주시 “차량에 조리식품 2시간이상 방치 안돼” |2023. 10.18 [종합] 광주시 “차량에 조리식품 2시간이상 방치 안돼” |2023. 10.18
[광산저널] 광주광역시보건환경연구원은 일교차가 큰 가을철에 식중독 발생 우려가 있어 위생관리에 주의해 줄 것을 당부했다.
실제 광주지역 최근 5년간(2018~2022년) 식중독 발생 현황을 분석한 결과, 발생건수는 여름철(6~8월)이 … |
|
 [종합] ‘끈끈한 경제공동체’ 광주시-함평군 함평천지한우로 상생·화합 다졌다 |2023. 10.18 [종합] ‘끈끈한 경제공동체’ 광주시-함평군 함평천지한우로 상생·화합 다졌다 |2023. 10.18
[광산저널] 광주시민과 함께하는 ‘2023 함평천지한우 소비촉진행사’가 18일 광주시-함평군 상생‧화합을 기치로 시청 앞 잔디광장에서 열렸다.
이 행사는 최근 한우가격 하락과 사료가격 상승으로 이중고를 겪고 있는 한우 사… |
|
 [종합] 광산구, 청년 자격증 취득비용 지원 |2023. 10.18 [종합] 광산구, 청년 자격증 취득비용 지원 |2023. 10.18
[광산저널] 광주 광산구(구청장 박병규)가 20~30대 청년 구직활동의 경제적 부담을 완화하고, 취업역량 강화를 돕고자 ‘청년 자격증 취득 지원사업’을 추진한다.
이 사업은 자기 계발에 필요한 수강료 및 응시료를 1인당 1회 최대 2… |
|
 [종합] 다문화가정 따뜻한 겨울나기 위한 주거환경개선 |2023. 10.18 [종합] 다문화가정 따뜻한 겨울나기 위한 주거환경개선 |2023. 10.18
[광산저널] 광주 광산구 평동(동장 김진학)은 노후주택에서 생활하고 있는 다문화가정의 따뜻한 겨울나기를 지원하기 위해 지역 기관‧단체와 주거환경을 개선한다고 밝혔다.
주거환경개선은 광주외국인노동자지원센터(이사장 김… |
|
 [종합] 광주시, 충민공 제396주기 제향 봉행 |2023. 10.19
[종합] 광주시, 충민공 제396주기 제향 봉행 |2023. 10.19
 [종합] 제32회 광산구민의 날, 최초로 시민 대표가 기념사 |2023. 10.19
[종합] 제32회 광산구민의 날, 최초로 시민 대표가 기념사 |2023. 10.19
 [종합] 광산구어린이급식지원센터, 사랑나무어린이집 원생 체험 교육 |2023. 10.19
[종합] 광산구어린이급식지원센터, 사랑나무어린이집 원생 체험 교육 |2023. 10.19
 [종합] 광주시, 23∼26일 ‘2023년 화랑훈련’ 실시 |2023. 10.19
[종합] 광주시, 23∼26일 ‘2023년 화랑훈련’ 실시 |2023. 10.19
 [종합] 예술성·대중성 조화…시민에 다가간 미디어아트 |2023. 10.19
[종합] 예술성·대중성 조화…시민에 다가간 미디어아트 |2023. 10.19
 [종합] 강기정 시장, 장애인아시안게임 광주선수단 응원 |2023. 10.19
[종합] 강기정 시장, 장애인아시안게임 광주선수단 응원 |2023. 10.19
 [종합] 호남대, ‘K-MOOC 미래기술 컨퍼런스 시즌 2’ 개최 |2023. 10.19
[종합] 호남대, ‘K-MOOC 미래기술 컨퍼런스 시즌 2’ 개최 |2023. 10.19
 [종합] 광주고려인마을 가족식당, 우즈벡 사마르칸트 고려인협회에 전통악기 기증 |2023. 10.19
[종합] 광주고려인마을 가족식당, 우즈벡 사마르칸트 고려인협회에 전통악기 기증 |2023. 10.19
 [종합] 박상철 호남대 총장, 한국대학스포츠협의회 이사회 참석 |2023. 10.18
[종합] 박상철 호남대 총장, 한국대학스포츠협의회 이사회 참석 |2023. 10.18
 [종합] 국제거리예술축제 ‘광주프린지페스티벌’ 20일 개막 |2023. 10.18
[종합] 국제거리예술축제 ‘광주프린지페스티벌’ 20일 개막 |2023. 10.18
 [종합] 빛고을안전체험관, 시청각자료 활용 소방안전교육 |2023. 10.18
[종합] 빛고을안전체험관, 시청각자료 활용 소방안전교육 |2023. 10.18
[종합] 광주시 “차량에 조리식품 2시간이상 방치 안돼” |2023. 10.18
[종합] 광주시 “차량에 조리식품 2시간이상 방치 안돼” |2023. 10.18
 [종합] ‘끈끈한 경제공동체’ 광주시-함평군 함평천지한우로 상생·화합 다졌다 |2023. 10.18
[종합] ‘끈끈한 경제공동체’ 광주시-함평군 함평천지한우로 상생·화합 다졌다 |2023. 10.18
 [종합] 광산구, 청년 자격증 취득비용 지원 |2023. 10.18
[종합] 광산구, 청년 자격증 취득비용 지원 |2023. 10.18
 [종합] 다문화가정 따뜻한 겨울나기 위한 주거환경개선 |2023. 10.18
[종합] 다문화가정 따뜻한 겨울나기 위한 주거환경개선 |2023. 10.18
 2026.03.25(수) 11:04
2026.03.25(수) 11:04









